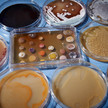
Antiinfektiva: Sanofi und Evotec forschen gemeinsam

Thema: Pharma
Artikel zum Thema
Pharmkonzerne Boehringer verkauft Werk in Spanien
Boehringer Ingelheim macht Einschnitte bei der Wirkstoffproduktion und trennt sich von seinem Werk im spanischen Malgrat. Die beiden anderen Werke in Ingelheim... Mehr»
Pharmakonzerne Sanofi holt Finanzchef von Peugeot
Sanofi bekommt einen neuen Finanzchef. Jean-Baptiste Chasseloup de Chatillon, bisher Finanzvorstand beim Autobauer PSA Peugeot Citroen, wird im September zum... Mehr»
Pharmakonzerne Bayer: Prozess gegen Monsanto wegen Krebsgefahr
Der jüngst vom Bayer-Konzern übernommene Saatgutriese Monsanto muss sich erstmals vor einem US-Gericht wegen angeblich verschleierter Krebsrisiken seines... Mehr»
Pharmaunternehmen Antiinfektiva: Sanofi und Evotec forschen gemeinsam
Das Hamburger Biotec-Unternehmen Evotec und der französische Pharmakonzern Sanofi bringen ihr geplantes Gemeinschaftsunternehmen an den Start. Beide Konzerne... Mehr»
Der Markt für Cannabis wächst und neue Importeure wollen sich in der Versorgung der Patienten mit Cannabisblüten etablieren. Zu den Neulingen gehört das... Mehr»
Pharmaunternehmen Baxter: Wechsel in der DACH-Geschäftsführung
Der Medizinproduktehersteller Baxter hat mit Magnus Lindholm einen neuen Geschäftsführer für das DACH-Gebiet. Seine Vorgängerin Manuela Hoffmann-Lücke hat das... Mehr»
Pharmakonzerne J&J verkauft Lifescan
Seit Anfang 2017 hat Johnson & Johnson (J&J) seine Planspiele für LifeScan öffentlich gemacht. Jetzt verkauft der US-Konzern die Sparte an den Finanzinvestor... Mehr»
Arzneimittelkosten Glaeske: Preisexplosion bei Krebsmitteln inakzeptabel
Muss die Hoffnung auf Krebsheilung mit einer Viertelmillion Euro pro Patient bezahlt werden oder geht es auch eine Nummer preiswerter? Nach Ansicht des... Mehr»
Arzneimittelengpässe Hamstern für den Brexit
Hersteller MSD rechnet offenbar mit Arzneimittelengpässen durch den Brexit: Einem Bericht der Wirtschaftsagentur Bloomberg zufolge plant der Pharmakonzern... Mehr»
Pharmakonzerne Valeant wird Bausch
Bereits seit zwei Jahren versucht der Pharmakonzern Valeant, sein angekratztes Image abzustreifen und nach zahlreichen Skandalen wieder auf Kurs zu kommen. Den... Mehr»